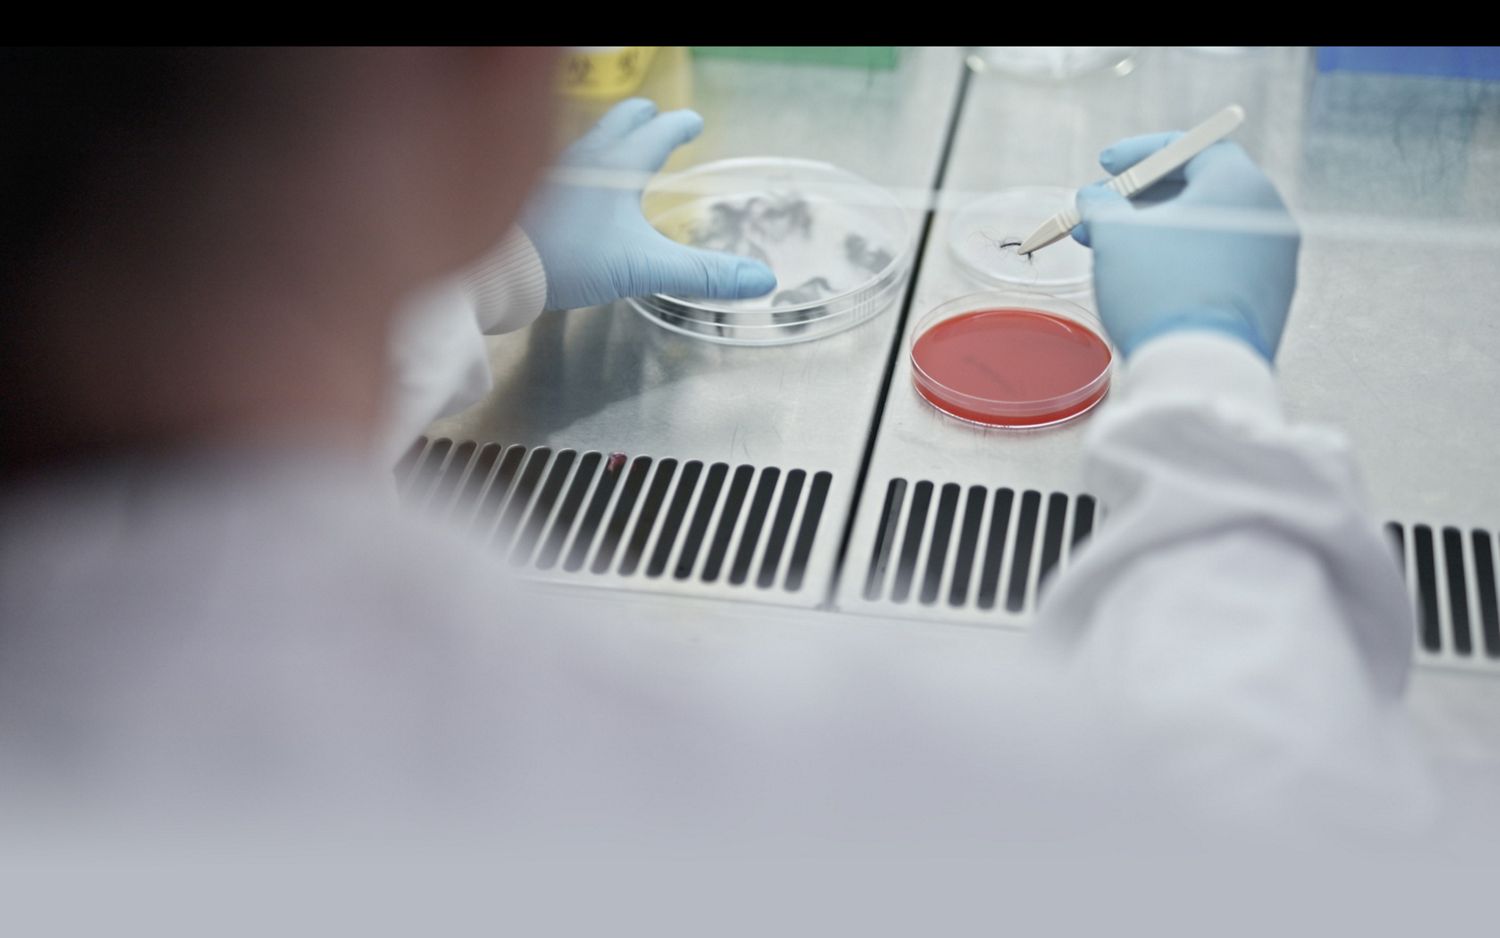
Microbiologistes de Dyson qui étudient des particules microscopiques.

Science des animaux
Les microbiologistes de Dyson étudient comment la saleté, les squames d'animaux et autres particules sont propagés par les poils des animaux afin de trouver de meilleures solutions pour les capturer et limiter leur propagation.


Dyson nettoie en profondeur partout où passent les animaux
Votre animal de compagnie laisse des poils et des particules aussi petites que des allergènes dans votre maison
Pollen
Des particules provenant de l'extérieur peuvent s'accumuler sur les pattes et les poils des animaux de compagnie qui les déposent ensuite à l'intérieur de votre habitation.
Bactéries
La saleté venant de l'extérieur peut coller aux poils des animaux de compagnie, entraînant la propagation de bactéries dans votre maison.
Squames
Les squames des animaux de compagnie sont un allergène composé de cellules de peau morte et de salive. Ils peuvent flotter dans l'air et se déposer sur les poils des animaux, les meubles, la literie et les tissus d'ameublement.
Poils d'animaux
Les poils d'animaux sont visibles mais pas toutes les saletés et autres matières qui peuvent s'y accrocher.

Révèle
Dyson révèle la poussière invisible et les poils d'animaux difficiles à repérer. La tête d'aspirateur éclairante rend visible la poussière sur les planchers durs, pour que rien ne vous échappe.
-

-
Dyson connaît les poils des animaux de compagnie
Nos scientifiques ont passé des années à analyser les différents types de poils, jusqu'à la façon dont ils se courbent, rebondissent et tombent.
-
Et sait comment les éliminer
La tête d'aspirateur Dyson Motorbar™ enfonce des picots de nylon rigides dans le tapis pour capturer les poils récalcitrants.
-
Sur toutes les surfaces
La poussière et les poils peuvent s'accrocher aux charges statiques des planchers durs. Les filaments antistatiques en fibre de carbone pénètrent en profondeur pour libérer les particules fines.
-

Capture puissamment
Démêle automatiquement. La puissante aspiration Dyson élimine la poussière, la saleté et les poils des animaux de compagnie.
-
Les animaux de compagnie ne perdent pas que des poils

-
Les poils des animaux de compagnie peuvent transporter des allergènes
Les poils que votre animal de compagnie perd peuventrépandre des allergènes microscopiques dans votre maison.
-
Dyson va plus loin
Nos microbiologistes étudient les particules qui peuvent s'accrocher aux poils des animaux de compagnie afin de trouver de meilleures solutions pour les capturer.
-
Pour une maison plus propre, plus hygiénique
C'est pourquoi les aspirateurs Dyson disposent des accessoires, de la puissance et de la filtration nécessaires pour capturer les particules invisibles et limiter leur propagation.
-
Outils et accessoires pour animaux de compagnie

-
Capture les poils détachés
Brosse et aspire les poils détachés de votre animal directement dans l'aspirateur.
-
Toilettage rapide et confortable
Les 364 picots inclinés à 35° se redressent lors du brossage.
-
Élimine les allergènes à chaque passage
Les cellules mortes de la peau sont capturées à chaque coup de brosse. Ainsi, elles sont retirées et ne s'éparpillent pas dans votre maison.
-

Mini brosse auto-démêlante
Développé par Dyson pour les aspirateurs sans fil. La mini brosse auto-démêlante élimine les poils longs et les poils d'animaux de compagnie des lits, des sièges de voiture et des escaliers. Rapide.
-

Brosse auto-démêlante
Développé par Dyson pour les aspirateurs traîneaux. Des brosses à rotation opposée enlèvent les cheveux et les poils des tapis et des tissus d’ameublement. Plus de nœuds.
¹ Filtration testée selon la norme ASTM F3150 en mode Boost.